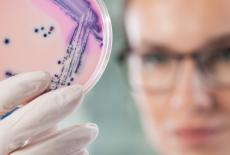
Lucruri neasteptate care au mai multi microbi decat ati crede

Cistitele repetate la femei, solutii numeroase in farmacii, dar care au sustinere stiintifica? Partea I

Dr. Andrei Manu Marin
medic primar urolog, doctor in stiinte medicale, specialist in neuro-urologie
Clinica: Evo-Med
Forme de cistite , cand si ce tratament alegem

Cistita, inflamatia vezicii urinare, este o afectiune extrem de suparatoare datorita simptomelor dureroase in timpul urinarii si a frecventei crescute a urinarilor.
Atunci cand se intampla sa si recidiveze, ceea ce se intampla relativ frecvent, pe langa simptomele suparatoare, se mai adauga si anxietatea ca nu se gaseste cauza si solutia potrivita de tratament. Frica de recidiva face ca multe femei sa isi schimbe activitatile cotidiene.
Exista mai multe forme de cistite care beneficiaza de tratamente diferite: cistita bacteriana, bacteriuria asimptomatica, cistita interstitiala
Cistita bacteriana si Bacteriuria asimptomatica
Pu tem vorbi de cistita bacteriana doar atunci cand un germene poate fi izolat la analiza numita urocultura. O urocultura pozitiva este analiza care stabileste diagnosticul de cistita bacteriana, ea identificand germenul cat si antibioticele la care acesta este sensibil (antibiograma).
tem vorbi de cistita bacteriana doar atunci cand un germene poate fi izolat la analiza numita urocultura. O urocultura pozitiva este analiza care stabileste diagnosticul de cistita bacteriana, ea identificand germenul cat si antibioticele la care acesta este sensibil (antibiograma).
Foarte important – Urocultura si tratamentul cu antibiotice nu trebuie facute decat in prezenta unei simptomatologii (durere, usturime la urinare, urinare frecventa, urina tulbure sau a indicatiei medicului.
Exista frecvent uroculturi pozitive fara simptomatologie, asa numita bacteriurie asimptomatica, la care tratamentul cu antibiotice este inutil si duce la aparitia rezistentei microbiene.
Ghidul din 2018 al Asociatiei Europene de Urologie (EAU) nu recomanda tratament antibiotic in caz de urocultura pozitiva (bacteriurie) asimptomatica, la urmatoarele tipuri de pacienti1 :
• femei la menopauza, si pre-menopauza, non-gravida
• femeile diabetice
• subiectii institutionalizati varstnici
• persoanele cu leziuni ale maduvei spinarii
• pacientii cu cateter urinar permanent
Chiar in cazul unor cistite recidivante este recomandat ca atunci cand exista un episod fara simptome urinare suparatoare, sa nu se dea antibiotic, chiar daca urocultura este pozitiva, considerandu-se ca echilibrul microbiotei din vezica urinara nu trebuie alterat.
Majoritatea cistitelor simple necomplicate sunt cauzate de bacteria E. Coli (>80%). Majoritatea tulpinilor de E. Coli care cauzeaza cistita provin din flora intestinala a  pacientilor si sunt diferite de tulpinile care cauzeaza alte infectii (de exemplu digestive).
pacientilor si sunt diferite de tulpinile care cauzeaza alte infectii (de exemplu digestive).
Ele se numesc tulpini E.coli uropatogene si s-a demonstrat2 ca ele au un comportament specific
• pot exista in flora intestinala normala fara a determina manifestari, unde se dezvolta si capata niste factori specifici de virulenta
• in anumite situatii ,care tin de gazda sau de mediu, numarul lor creste si devin predominante
• in cautarea unui mediu mai propice, in special la femeie, datorita uretrei scurte, pot cobora din rect, colonizeaza zona perineala si urca apoi in vezica unde pot declansa inflamatia daca depasesc mecanismele de aparare ale vezicii urinare.
Articole recomandate
-
 Cistita
Cistita
-
 Infectiile digestive cu Escherichia coli (E. coli)
Infectiile digestive cu Escherichia coli (E. coli)
-
 E. coli si sarcina
E. coli si sarcina
-
 Caravana medicala „Obezitatea este o boala” aduce evaluari gratuite in I ...
Caravana medicala „Obezitatea este o boala” aduce evaluari gratuite in I ...
-
 Noi ceasuri inteligente care te ajuta sa-ti intelegi mai bine organismul si ...
Noi ceasuri inteligente care te ajuta sa-ti intelegi mai bine organismul si ...
-
 Infectia cu Escherichia coli
Infectia cu Escherichia coli
-
 Cistita – care sunt semnele, factorii de risc si tratamentul?
Cistita – care sunt semnele, factorii de risc si tratamentul?
-
 Infectiile de tract urinar la femei - cistita acuta, cronica, interstitiala, ...
Infectiile de tract urinar la femei - cistita acuta, cronica, interstitiala, ...
Prezenta lor in flora intestinala normala, precum si factorii de virulenta specifici, pot fi explicatii plauzibile pentru rata mare de recidiva a infectiilor urinare
Disparitia unei infectii din vezica urinara cu simptomatologie se poate obtine doar prin tratament cu antibiotice, antibioticul trebuind sa fie ales conform antibiogramei (test efectuat simultan cu urocultura).
Pentru o cistita simpla, adica fara febra sau sangerare, antibioticul trebuie luat 3 zile.
Impreuna cu antibioticul, sau dupa, pot fi administrate produsele care au ca rol reducerea incarcaturii bacteriene de la nivel intestinal si urinar, mentionate.
Profilaxia recidivelor se face prin masurile de igiena pe care le vom mentiona in partea a 2 a dar si prin administrarea de solutii care au ca rol reducerea rezervorului de E. Coli de la nivel intestinal .
Cistita Interstitiala - vezica dureroasa cronica
Este o cistita la care exista simptome de cistita dar cu urocultura sterila.
Este o cistita mult mai suparatoare, cauzata de aparitia unei „iritatii” in interiorul vezicii, care devine dureroasa in contact cu urina. Pacienta (pentru ca apare cel mai des la femei) simte dureri exact ca la cistita clasica, dureri care se intensifica pe masura ce se umple vezica, ceea ce o face sa se duca mai des la toaleta, pentru a scapa de disconfort.
In stadiile incipiente, suferinta poate aparea sub forma de crize de durere si urinat des, saptamanale sau lunare, care se amelioreaza la caldura si se agraveaza la frig, dupa consumul alimentelor condimentate si acre sau dupa un contact sexual. Pacienta se gandeste imediat la o posibila cistita, dar urina, la analiza, nu este infectata.
In acest caz este necesar vizita la urolog pentru diagnostic si tratament corespunzator_104_32.jpg)
Mai multe informatii puteti citi pe www.evo-med.ro, www. Cistita.ro
Referinte
1. https://uroweb.org/wp-content/uploads/EAU-Guidelines-on-Urological-Infections-2018-large-text.pdf(https://uroweb.org/wp-content/uploads/EAU-Guidelines-on-Urological-Infections-2018-large-text.pdf
2. Relationship between E.Coli Strains causing acute Cystitits in Women and the Fecal E.Coli Population of the host-Moreno et al. Journal of Clinical Mikrobiology, Aug. 2008 p. 2529 – 2534
Profilaxia recidivelor se face prin masurile de igiena mentionate mai sus dar si prin administrarea de solutii care au ca rol reducerea rezervorului de E. Coli de la nivel intestinal :
Doar solutiile care vizeaza si intestinul sunt cu adevarat eficiente si pot preveni recidivele!
Utipro Plus, un produs nou inovativ, contine trei ingrediente naturale: Xiloglucan gelatina (mucoprotector) + hibiscus + propolis. Spre deosebire de celelalte tratamente non antibiotice, Utipro plus actioneaza in primul rand asupra originii infectiei, la nivel intestinal.
Mucoprotectoarele sunt polimeri ce actioneaza in acelasi fel ca bariera naturala de mucina (mucomimetic). Protejeaza mecanic epiteliul prevenind adeziunea agentilor patogeni si patrunderea lor masiva. In plus agentii patogeni care deja au patruns sunt izolati si neutralizati de sistemul imunitar propriu.
Drept urmare , Utipro Plus, prin xiloglucan gelatina, actioneaza mecanic formand un film protector care previne atasarea si proliferarea bacteriilor si astfel ascensiunea ulterior la nivelul vezicii urinare.
Utipro Plus contine si propolis si hibiscus care actioneaza la nivelul vezicii urinare, producand acidifierea urinei care duce la suprimarea proliferarii bacteriene.

Compusul este destinat controlului si prevenirii infectiilor tractului urinar produse de agenti patogeni, precum E. coli si alte bacterii gram negative implicate in mod normal in etiologia infectiilor tractului urinar.
Utipro plus este un dispozitiv medical marca CE, disponibil in farmacii. Pentru mai multe informatii referitoare la efectele sau la posibilele efecte secundare, adresati-va medicului sau farmacistului si cititi prospectul din interiorul ambalajului.
Mai multe informatii https://www.montavit.ro/ro/produse/dispozitive-medicale/utipro-plus
Opiniile exprimate in acest material apartin partenerului nostru. Aceste opinii pot sa nu reprezinte pozitia SfatulMedicului.ro si nici sugestie de achizitie. Va sfatuim ca pentru orice problema medicala, sa consultati intotdeauna un medic, inainte de a incepe sau a schimba un plan de tratament.
Articole recomandate
-
 Cistita: cauze, simptome, tratament si preventie
Cistita: cauze, simptome, tratament si preventie
-
 Infectia urinara cu Escherichia Coli
Infectia urinara cu Escherichia Coli
-
 Cistita interstitiala: nu ignorati durerea pelvina
Cistita interstitiala: nu ignorati durerea pelvina
-
 Cistita acuta simpla: simptome in cazul femeilor si al barbatilor
Cistita acuta simpla: simptome in cazul femeilor si al barbatilor
-
 Alocatiile complementara si de sustinere pentru familia monoparentala
Alocatiile complementara si de sustinere pentru familia monoparentala
-
 Dinti ficsi in 24 de ore: in ce consta tratamentul si cand este indicat
Dinti ficsi in 24 de ore: in ce consta tratamentul si cand este indicat
-
 Lucruri neasteptate care au mai multi microbi decat ati crede
Lucruri neasteptate care au mai multi microbi decat ati crede
-
 Laparoscopia in obstetrica-ginecologie
Laparoscopia in obstetrica-ginecologie


 Cistita
Cistita
 Infectiile digestive cu Escherichia coli (E. coli)
Infectiile digestive cu Escherichia coli (E. coli)
 E. coli si sarcina
E. coli si sarcina
 Caravana medicala „Obezitatea este o boala” aduce evaluari gratuite in I ...
Caravana medicala „Obezitatea este o boala” aduce evaluari gratuite in I ... Noi ceasuri inteligente care te ajuta sa-ti intelegi mai bine organismul si ...
Noi ceasuri inteligente care te ajuta sa-ti intelegi mai bine organismul si ... Infectia cu Escherichia coli
Infectia cu Escherichia coli
 Cistita – care sunt semnele, factorii de risc si tratamentul?
Cistita – care sunt semnele, factorii de risc si tratamentul?
 Infectiile de tract urinar la femei - cistita acuta, cronica, interstitiala, ...
Infectiile de tract urinar la femei - cistita acuta, cronica, interstitiala, ...
 Cistita: cauze, simptome, tratament si preventie
Cistita: cauze, simptome, tratament si preventie
 Infectia urinara cu Escherichia Coli
Infectia urinara cu Escherichia Coli
 Cistita interstitiala: nu ignorati durerea pelvina
Cistita interstitiala: nu ignorati durerea pelvina
 Cistita acuta simpla: simptome in cazul femeilor si al barbatilor
Cistita acuta simpla: simptome in cazul femeilor si al barbatilor
 Alocatiile complementara si de sustinere pentru familia monoparentala
Alocatiile complementara si de sustinere pentru familia monoparentala
 Dinti ficsi in 24 de ore: in ce consta tratamentul si cand este indicat
Dinti ficsi in 24 de ore: in ce consta tratamentul si cand este indicat Lucruri neasteptate care au mai multi microbi decat ati crede
Lucruri neasteptate care au mai multi microbi decat ati crede
 Laparoscopia in obstetrica-ginecologie
Laparoscopia in obstetrica-ginecologie

